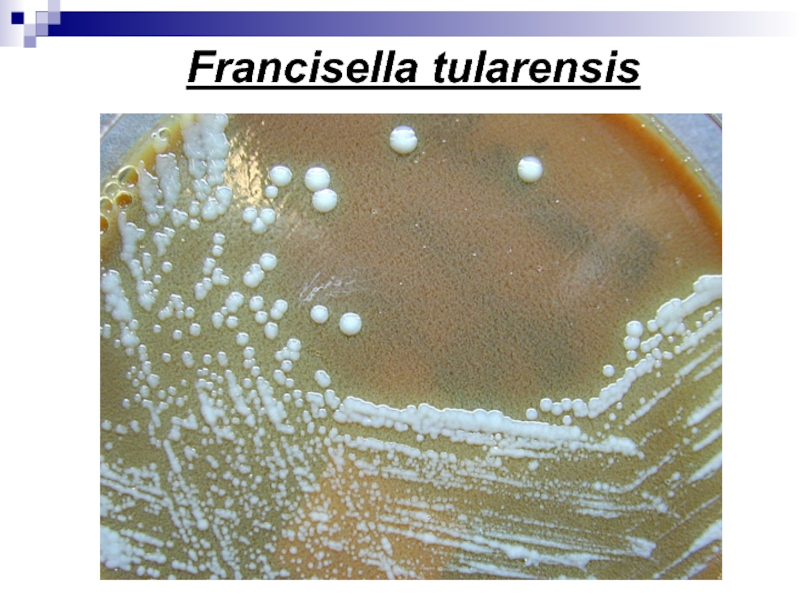

Слайд 1Микробиология бруцеллёза и туляремии
ПРАКТИЧЕСКОЕ ЗАНЯТИЕ №10
Частная микробиология
Для студентов ОмГМА
Слайд 2Микробиология бруцеллёза
Бруцеллёз – острое или хроническое антропозоонозное инфекционное заболевание, относится
к ООИ II группы патогенности; характеризуется интоксикацией, преимущественным поражением
опорно-двигательного аппарата, нервной, сердечно-сосудистой, мочеполовой систем и других органов, аллергизацией организма, затяжным течение, приводящим, как правило, к инвалидизации.
Возбудители бруцеллёза – бруцеллы открыты в 1886 г. Д.Брюсом.
Слайд 3Эпидемиология
Бруцеллёз распространен на всех континентах.
Резервуар в природе – с/х
и домашние животные (крупный и мелкий рогатый скот, свиньи, реже
олени, лошади, собаки, кошки).
Источник - больные с/х и домашние животные
Больной человек не заразен и является биологическим тупиком.
Восприимчивость у человека к возбудителю высока. Пути передачи и механизмы передачи–различные, чаще:
фекально-орально,
пищевым путём,
контактно.
Заболеваемость бруцеллёзом спорадическая или в виде вспышек.
Инкубационный период от 1-3 недель до нескольких месяцев.
Возбудители бруцеллёза – бруцеллы, относятся к
Роду Brucella
Слайд 4Классификация
Род Brucella, который включает в себя
виды:
B.melitensis (бруцелла распространена среди мелкого
рогатого скота, вызывает наиболее тяжелые поражения у человека). Имеет –
3 биовара.
B.abortus (возбудитель бруцеллёза у крупного рогатого скота; в основном -хронический бруцеллез). Имеет – 9 биоваров.
B.suis (возбудитель бруцеллёза свиней). Включает 4 биоваров
B.canis (собаки)
B.neotomae ( олени, грызуны)
B.ovis (овцы)
Для человека наибольшее значение имеют B.melitensis, B.abortus, B.suis.
Слайд 5Морфология
Бруцеллы – мелкие грамотрицательные микробы шаровидной, овальной и палочковидной формы.
Неподвижные
Спор
не образуют
Могут образовывать нежную капсулу под действием специфического бактериофага или
при выращивании на среде с 10% иммунной сывороткой.
Устойчивы в окружающей среде: от 45 до 60 дней (молоко и др.); в замороженном мясе – более 5 месяцев; в воде, почве – 5 и 3 месяцев соответственно.
Малоустойчивы к высокой температуре: при кипячении гибнут моментально; при 600 С через 30 минут.
Чувствительны к большинству антибиотиков и дезинфектантов.
Слайд 7Культуральные свойства.
Аэробы
На простых средах не растут
Растут замедленно, посевы инкубируют
не менее 3 недель.
Рост бруцелл на жидких средах сопровождается равномерным
помутнением сред.
Бруцеллы требовательны к питательным средам.
Лучше растут на сложных обогащенных средах с добавлением крови или сыворотки крови, глюкозы, глицерина (сывороточно-декстрозный и кровяной агары): печеночный агар Хеддельсона, 5% кровяной агар, мясопептонный бульон.
На 5% КА гемолиз не дают.
Пигмента не образуют.
Температурный оптимум 37 0 С.
Оптимум рН=6,6-7,4
Колонии возбудителя на плотных питательных средах растут:
- в S- форме мелкие, выпуклые, гладкие, с перламутровым оттенком, голубовато-серые, полупрозрачные, могут лизироваться бруцеллёзным бактериофагом;
при диссоциации образуют шероховатые R- формы колоний;
- наблюдаются диссоциации от S к R – формам.
Слайд 8Рост B. melitensis
На 5% КА
гемолиз
не образуют
Слайд 9Биохимическая активность очень низкая
Бруцеллы образуют ферменты:
Уреазу +,
Фосфатазу +,
Каталазу
+;
ферментируют углеводы в зависимости от видовой принадлежности: галактозу, рибозу, глюкозу,
ксилозу, арабинозу
при дифференциации на виды и биотипы используют дополнительные признаки, в т.ч. способность расти на средах, в присутствии красителей, обладающих бактериостатическим действием на отдельные виды бруцелл: основной фуксин, тионин, сафранин;
выделяют сероводород;
окисляют различные аминокислоты в зависимости от видовой принадлежности (аргинин, лизин), аланин, аспаргин, глютаминовую кислоту;
редуцируют нитраты в нитриты;
реакция VP – отрицательная;
некоторые виды требуют для роста СО2
Слайд 10Антигенная структура
Бруцеллы имеют общий соматический ОAg родоспецифический антиген, поэтому
бруцеллы разных видов дают перекрестную агглютинацию и капсульный К Аg.
Два
главных поверхностных антигена:
А (преобладает у B.abortus)
М (преобладает у B.melitensis) встречаются в различных количественных соотношениях у различных видов бруцелл. Для их идентификации используют антисыворотки.
Бруцеллы имеют поверхностный L Аg - антиген (сходен с Vi - антигенами сальмонелл).
Шероховатые формы содержат специфический R Аg - антиген, для его идентификации используют специфические антисыворотки, применяемые при серотипировании. (Колонии B.canis, B.ovis и B.suis 5 биотипа всегда имеют R- формы).
Многие антигенные фракции бруцелл обладают выраженным аллергизирующим действием.
У бруцелл имеются перекрестнореагирующие антигены с возбудителем туляремии, Bordetella bronchiseptica и Y.enterocolitica серотипа 09.
Слайд 11Факторы патогенности
Бруцеллы – факультативные внутриклеточные паразиты млекапитающих.
Обладают высокой инвазивной
способностью.
Патогенность бруцелл связана с наличием:
эндотоксина;
ферментов: гиалуронидазы, уреазу,
фосфатазу, каталазу;
наличием низкомолекулярных продуктов, способствующих подавлению фагоцитоза и окислительного взрыва в макрофагах;
наличием аллергизирующих субстанций.
Слайд 12Патогенез бруцеллёза
По лимфатическим путям бруцеллы попадают в регионарные лимфоузлы, где
размножаются в макрофагах, частично подвергаются внутриклеточному уничтожению.
Продукты жизнедеятельности бруцелл
ингибируют фагосомо - лизосомальное слияние. Морфологически в лимфоузлах формируется “первичный бруцеллезный комплекс” с формированием гранулем Новицкого с преобладанием крупных эпителиоидных клеток. Из разрушенных макрофагов в лимфоузлах бруцеллы попадают в кровь, распространяются по организму и поражают лимфатическую систему, печень, селезенку, нарушаются функции опорно-двигательного аппарата, нервной и половой систем.
Болезнь может иметь длительное хроническое течение (по сути - хрониосепсис).
В патогенезе бруцеллеза имеет значение цикличность процессов, связанных с повторными проникновениями бруцелл в кровь из очагов с развитием местной воспалительной и общей реакций, на формирование которых существенное влияние оказывает специфическая сенсибилизация (реакция ГЗТ).
Существенное значение в патогенезе, кроме аллергической перестройки и интоксикации, имеет преимущественное вовлечение в инфекционный процесс тех или иных органов и тканей.

Слайд 13Патогенез бруцеллёза. Внутриклеточное расположение возбудителя.
Слайд 14Иммунитет
Клеточно-гуморальный
Нестерильный и относительный
Возможна реинфекция
Лечение
Антибиотики широкого спектра действия со стрептомицином при
наличии бактериемии (При хроническом бруцеллёзе А/б не эффективны из-за внутриклеточного
расположения бактериальных клеток).
Специфическая иммунотерапия:
убитой лечебной бруцеллёзной вакциной ( 5-7 в/в вливаний в нарастающих дозах 1-2 раза в неделю);
бруцеллином (в/м по 2 раза в неделю);
При острых и рецидивирующих формах назначают бруцеллёзный иммуноглобулин.
Специфическая профилактика
Вакцинация по э/показаниям живой бруцеллезной ослабленной вакциной ЖБВ П.А.Вершиловой из штамма ВА-19А из B.abortus и создающую перекрёстный иммунитет против других видов бруцелл. Разработана химическая бруцеллезная вакцина, которая отличается от живой вакцины более низкой реактогенностью.
Неспецифическая профилактика
Санитарно-ветеринарные мероприятия
Слайд 15Материал для исследования:
Кровь, пунктат, красного костного мозга испражнения,
молоко-молочные продукты, кусочки органов.
Методы лабораторного исследования:
1. бактериоскопический
2. бактериологический
3. биологический
4. экспресс-метод
5.
серологический
6. аллергологический.
5 и 6 методы проводятся в базовых лабораториях, остальные в специальных лабораториях ООИ.
Лабораторная диагностика бруцеллёза
Слайд 16Серологический метод
В сыворотке больных накапливаются агглютинирующие (вначале IgM, затем IgG),
неполные блокирующие (IgA и IgG) и опсонические (IgG) антитела.
Для их
выявления с диагностической целью используют:
- реакцию Райта DS титр = 1:200 (развёрнутая агглютинация) – положительная спустя 1-2 нед после начала заболевания, сохраняется на долгие годы.
реакция Хеддельсона (пластинчатая агглютинация) – для ускоренной серодиагностики с неразведённой сывороткой больного и концентрированным Ag-диагностикумом, окрашенным метиленовым синим.
Стекло 9х12см : на 5 квадратов, куда вносят микропипетками ингредиенты, после их перемешивания палочкой, стекло прогревают над горелкой до 37 гр С – 2 мин. При + результате = хлопья синего цвета. Реакция положительная при наличии агг-ции на «++» в дозах сыворотки 0,02-0,01 мл.
Лабораторная диагностика бруцеллёза
Слайд 17 Лабораторная диагностика бруцеллёза
Серологический метод
Постановка пластиночной РА Хеддельсона
Слайд 18РПГА,
РИФ
ИФА,
Реакция Кумбса, определения неполных антител
Опсонофагоцитарную реакцию.
В поздние сроки –
РА, РНГА, РСК
При массовых обследованиях реакцию Хеддельсона проводят в сочетании
с кожно-аллергической пробой Бюрне.
Проба Бюрне (её ставят с 15-20 дня).
На ладонную поверхность предплечия в/к вводят 0,1 мл бруцеллина. При ГЗТ через 6-8 час появляется гиперемия кожи и болезненная отёчность. Учёт реакции через 24 час. ( недостаток – положительна у больных, переболевших и у вакцинированных)
Реакцию Хеддельсона не заменяет пробу Бюрне.
В ранние сроки определяют IgM, в более поздние – IgG.
Экспресс-методы: ПЦР
Лабораторная диагностика бруцеллёза
Слайд 19Проба Бюрне
Кожно – аллергические пробы.
Для диагностики распространенных форм немедленной аллергии
применяют скарификационные и prick – тесты кожного тестирования. При выявлении
ГЗТ используют внутрикожный тест с аллергенами микробов (с туберкулином, бруцеллином, токсоплазмином и др.). Реакция оценивается через 24-48 часов.
Слайд 20Реакция Кумбса
Реакция Кумбса - непрямая реакция агглютинации для определения антирезусных
(неполных) антител . У некоторых больных обнаруживают антирезусные антитела, которые
являются неполными, одновалентными. Они специфически взаимодействуют с резус-положительными эритроцитами (Rh + ), но не вызывают их агглютинации. Для этого в систему «антирезусные антитела + резус- положительные эритроциты» добавляют антиглобулиновую сыворотку (антитела против иммуноглобулинов человека), что вызывает аглютинацию эритроцитов .
Слайд 21 Лабораторная диагностика бруцеллёза
ИМ
Гр-кокко
бациллы
Экспресс-
методы:
- РИФ
- ИФА
- ПЦР
- Латекс-агглютинация
- Ко-агглютинация
РТП
– Реакция термопреципитации
по Асколи для выявления соматического антигена
Аллергический
метод:
Проба Бюрне
МПБ
МПА
с печёночным
переваром
Бактериологический метод:
370 С от 4-5 дней до 30 дней
Посев по 2 чашки без и с + 10% СО2
Рост в виде R, S – форм
МПА
С переваром
печени
Чистая культура
Биопроба: На белых мышах, морских свинках. Осадок мочи и молоко п/к.
Через 20-30 дней берут кровь для РА (развёрнутая и пластинчатая ). Забивают животных, делают посевы крови из сердца, взвесь внутренних органов и лимфоузлов (или мазки-отпечатки из органов погибших животных).
На предметные стёкла
На питательные среды
МПА с печён
МПБ
МПА
с печён
б-ном
и пеницил
РИФ, ПЦР, ИФА,
Ферментативная активность низкая:
гемолиз (-)
фосфотаза (+)
Уреаза (+)
Каталаза (+):
Биохимическая активность:
глюкоза (+-),
Арабиноза (+-),
галактоза (+-),
рибоза (-+ )
Ксилоза (+-),
восстанавливают нитраты в нитриты (+)
VP (-).
сероводород (+)
Н2О2
С
фуксином
Эритрит
агар
С
тионином
МПА и печёночнымйбульон
МПА
с печёночным
переваром
МПА
С глицерином
МПА
С глицерином
12 дневные
куриные
эмбрионы
Эритрит
агар
5% КА
Чув
к фагу
Чув
к А/б
Печё
Б-н
Кровь сеют на гемокультуру в 50 мл Печ б-на

Слайд 23Туляремия
- это острое или хроническое системное природно-очаговое заболевание человека и
животных, которое характеризуется лихорадкой, интоксикацией и поражением лимфотических узлов.
Возбудитель
Francisella tularensis
Род Francisella
Слайд 24Francisella tularensis
Возбудитель открыт в 1911 г. Г.Мак-Коем и Х.Чепином.
Детально
изучен Э.Френсисом.
Семейство Brucellacea
Род Francisella
Выделяют 3 подвида туляремийного возбудителя по
вирулентности для кроликов и биохимическим особенностям, а также географическому распространению (эколого-географические расы):
Голарктический (Европа, Азия и Севереная Америка) – умеренно патогенный для домашних кроликов, который делится на биовары:
Японский (Японские острова);
эритромициночувствительный и чувствительный к антибиотикам-макролидам ( Европа, Азия, Северная Америка);
эритромицинустойчивый (Восточная Европа и Западная Сибирь).
Среднеазиатский (долина рек Средней Азии) – умеренно патогенный для домашних кроликов;
Неарктический или американский (Северная Америка) -высокопатогенный для домашних кроликов.
Слайд 25Эпидемиология
Основной вид - F.tularensis - возбудитель туляремии - природноочаговой инфекции.
Резервуар - многие виды преимущественно мелких диких позвоночных животных (представителей
четырех основных семейств - мышевидных, заячьих, беличьих и тушканчиковых).
На территории России основными носителями являются мышевидные грызуны - водяные крысы, ондатры, различные виды полевок.
Могут заражаться овцы, свиньи, крупный рогатый скот.
Помимо F. tularensis к этому роду относится F. novicida, патогенность которой для человека не доказана.
Слайд 26Эпидемиология
На территории России выделено 7 основных ландшафтных типов природных очагов
туляремии: пойменно-болотный, луго - полевой, степной, лесной, предгорно-ручьевой, тундровый и
тугайный (пойменно-пустынный) со своими основными хозяевами возбудителя и эколого-эпидемиологическими особенностями.
Человек очень чувствителен к туляремийному микробу, минимальная инфицирующая доза - одна микробная клетка.
Животные по чувствительности к этому микроорганизму разделены на четыре группы.
Особое значение в условиях Западной Сибири имеют водяные крысы и ондатры.
Заражение человека может происходить путем контакта с грызунами или инфицированными ими предметами, алиментарным путем (инфицированные грызунами вода и пищевые продукты), воздушно - пылевым путем (аэрозольно), трансмиссивно (иксодовые клещи и другие кровососы).
Н.Г.Олсуфьев выделяет две экологические формы возбудителя - “сухопутную”, характеризующуюся передачей через иксодовых клещей (все три подвида), и “водную”, связанную с околоводными видами грызунов и другими организмами - гидробионтами, с преимущественной передачей через воду и укусы комаров (голарктический подвид).

Слайд 27Морфология
Франциселлы - мелкие кокковидные или элипсоидные полиморфные палочки,
неподвижные,
грамотрицательные,
не образующие спор.
Слайд 28Факторы патогенности
Возбудитель туляремии является внутриклеточным паразитом.
Вирулентность обусловлена:
- капсулой,
угнетающей фагоцитоз;
- нейраминидазой, способствующей адгезии;
- эндотоксином (интоксикация);
- аллергенными свойствами клеточной
стенки;
- способностью размножаться в фагоцитах и подавлять их киллерный эффект;
- наличием рецепторов к Fc- фрагменту IgG, подавлять активность систем комплемента и макрофагов.
Слайд 29Francisella tularensis
Грам «-» палочки
овоидной формы
Слайд 31Культуральные свойства.
Строгие аэробы или факультативные анаэробы,
оптимум температуры около +37-380С,
pH - близкая к нейтральной 6,8-7,4.
Культивируются на агаровых и желточных
средах сложного состава с добавлением цистеина, глюкозы, крови (Мак-Коя, Чепина, Френсиса, Анциферова, Емельяновой, )
Рост медленный.
Образуют мелкие колонии, напоминающие капельки росы, круглые с ровным краем, выпуклые, блестящие, с голубоватым отливом или молочно-белого цвета.
Хорошо культивируются в желточном мешке куриного эмбриона.
При культивировании на искусственных питательных средах происходит аттенуация бактерий и превращение их из вирулентной S-формы в авирулентную и неиммуногенную R-форму.
Вакцинные штаммы – SR-формы.
Слайд 33Биохимическая активность
Слабо ферментируют до кислоты без газа некоторые углеводы:
глюкозу,
мальтозу,
левулёзу,
маннозу,
Образуют сероводород.
Подвиды туляремийного микроба отличаются по
биохимическим особенностям:
голарктический - не ферментирует глицерин, цитруллин;
неарктический - ферментирует глицерин, не ферментирует цитруллин;
среднеазиатский - ферментирует глицерин и цитруллин,
Слайд 34Антигенная структура
F.tularensis в S (вирулентной) форме имеет два основных антигенных
комплекса - О антиген (обнаруживает сходство с О - антигенами
бруцелл) и Vi (капсульный) антиген.
Диссоциация S R приводит к утрате капсулы, вирулентности и иммуногенности.
Слайд 36Клиника и патогенез туляремии
Франциселлы проникают в организм через кожу и
слизистые глаз, рта, дыхательных путей, желудочно-кишечного тракта.
Выделяют следующие стадии
в патогенезе туляремии (Г.П.Руднев (1970) :
1. Внедрения и первичной адаптации возбудителя.
2. Лимфогенного заноса.
3. Первичных регионарно - очаговых (туляремийный бубон) и общих реакций.
4. Гематогенных метастазов и генерализации.
5. Вторичной полиочаговости.
6. Реактивно - аллергических изменений.
7. Обратного метаморфоза и выздоровления.
В ряде случаев процесс может ограничиваться первыми тремя фазами.
Слайд 37Клиника и патогенез туляремии
Основные клинические формы туляремии:
язвенно-бубонная (ульцерогландулярная),
глазо-бубонная (окулогландулярная),
легочная,
абдоминальная,
генерализованная, другие формы (в т.ч. ангинозно-гландулярная),
неуточненная
(международная статистическая классификация
болезней, 10 пересмотр. ВОЗ, 1995).
Слайд 38Лабораторная диагностика туляремии
Биологический материал для исследования определяется формой болезни:
кровь,
пунктат из
бубона,
соскоб из язвы,
отделяемое с коньюнктивы,
налёт из зева, мокрота и т.д,
Материал
из ООС:
вода,
пищевые продукты
Слайд 39Лабораторная диагностика туляремии
Исследования проводят в режимных лабораториях.
Методы диагностики туляремии у
человека :
1.Бактериологический метод имеет дополнительное значение и не всегда эффективны,
что определяется биологическими особенностями возбудителя и особенностями инфекции у человека (малая концентрация возбудителя в органах и тканях).
Чистую культуру бактериологическим методом выделяют после накопления её на восприимчивых животных - биологический метод.
2. Биологический метод более эффективный метод диагностики. Заражают белых мышей п/к, морских свинок – в/б или заражают 12 дневные куриные эмбрионы.
Животные погибают на 3-6 день, могут позже до 14 дней. Животных вскрывают, наблюдают патологоанатомические изменения с некрозом. Выделяют чистую культуру из органов делая мазки-отпечатки на плотные питательные среды (желточная, глюкозоцистеиновый кровяной агар, среда Емельянова и др.).
Слайд 40Лабораторная диагностика туляремии
3.Бактериоскопический метод. Окраска по Граму, мазков-отпечатков органов -
по Романовского-Гимзе (внутриклеточное расположение бактерий с нежной капсулой).
4.Серологический метод: РА,
РПГА, РСК на холоде, РИФ, РНАТ. Обязательно исследование парных сывороток крови
5.Аллергические пробы (Аллергодиагностика)- накожный и внутрикожный способы введения тулярина : для ранней диагностики туляремии – с 5 дня от начала болезни. Учёт через 24-36-48 часов. Положительный результат – инфильтрат не менее 5 мм.
У больных накожные и внутрикожные туляриновые пробы не рекомендуются в связи с возможностью ухудшения состояния больного.
Могут применяться методы аллергодиагностики in vitro - реакция лейкоцитолиза, РТМЛ и др.
6.Экспресс-методы: ИФА, ПЦР, Латекс-агглютинация, Ко-агглютинация
Слайд 41Лабораторная диагностика туляремии
Культуру идентифицируют по совокупности следующих признаков:
морфология клеток
и грамотрицательная окраска;
рост на желточной среде и специальных средах
отсутствие роста - на простых мясо - пептонных средах;
специфическое свечение в реакции иммунофлюоресценции (МФА);
агглютинация культуры туляремийной сывороткой;
способность вызывать гибель белых мышей и морских свинок с характерными патологоанатомическими изменениями в органах и выделением чистой культуры.
Слайд 42Лечение
Для лечения применяют антибиотики стрептомицинового и тетрациклинового ряда.
В случаях
затяжного течения проводят комбинированную антибиотикотерапию и вакцинотерапию с применением убитой
лечебной вакцины.
Специфическая профилактика.
На неблагополучных по туляремии территориях применяют живую туляремийную вакцину, полученную Б.Я. Эльбертом и Н.А.Гайским из штамма №15.
Иммунитет прочный, длительный, проверяется с помощью пробы с тулярином. С помощью этой пробы отбирают контингенты на вакцинацию по эпидпоказаниям и ревакцинацию лицам группы риска.
Неспецифическая профилактика
Как при природно-очаговых зоонозах и направлена на борьбу с грызунами
Слайд 43 Лабораторная диагностика туляремии
ИМ
Гр- палочки
Экспресс
-методы:
- РИФ
- ИФА
- ПЦР
- Латекс-агглютинация
Ко-агглютинация
Аллергический
метод:
Проба с тулярином
Мак-Коя
13 аминокислот
Чепина,
Емельяновой
Анциферова
370 С - 24 час до
10 суток
S-вирулентная
R-авирулентная формы
Мак-Коя
Чистая культура
Биопроба: На белых мышах (п/к) или морских свинках (вн/брюшинно). Животные погибают на 3-6 сутки
РИФ, ПЦР, ИФА,
Ферментативная активность:
глутаминаза (+)
аспарагиназа (+)
дезаминаза (+)
трансаминаза (+)
Каталазная активность (+):
Биохимическая активность низкая:
глюкоза (+),
мальтоза (+),
манноза (+-)
левулёза (+-)
маннит (-)
сероводород (+),
редукция метиленового синего (+),
Н2О2
5%КА
Чув
к А/б
мазки-отпечатки окраска
по Романовскому –
Гимзе
МПА
12 дневные
куриные
эмбрионы
по Граму
Забивают животных, делают посевы крови из сердца, взвесь внутренних органов и лимфоузлов (или мазки-отпечатки из органов погибших животных).
Слайд 44РТП – Реакция термопреципитации
по Асколи
Реакция используется для обнаружения сибиреязвенного
Ag.
РТП используется при наличии струпов, несвежего материала, шкур, павших животных.
Материалы
для исследования:
Преципитирующая сибиреязвенная сыворотка
Ag из испытуемого материала
Сибиреязвенный бактерийный Ag для контроля
Слайд 45РТП – Реакция термопреципитации
по Асколи
Схема постановки.
Испытуемый
материал
Экстракт
Ag
+
к
-
к
-
к
-
к